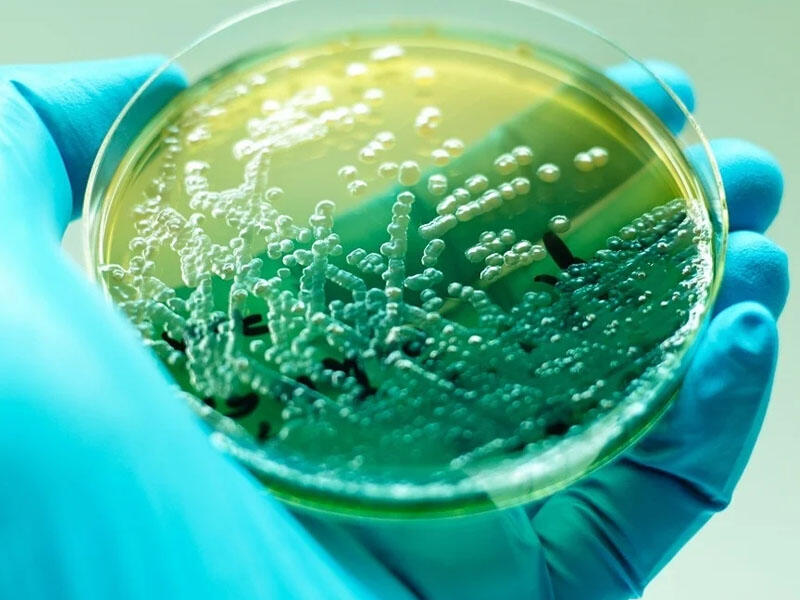
Ölümcül xəstəliklərə qarşı sadə bir vasitə tapıldı

Ölümcül xəstəliklərə qarşı sadə bir vasitə tapıldı
İngiltərənin "Surrey" Universitetinin alimləri, yaşıl çayda olan təbii antioksidantın antibiotiklərə qarşı davamlı olan, təhlükəli infeksiyalara qarşı mübarizədə faydalı ola biləcəyini müəyyən edib. Bu barədə "MedicalXpress" agentliyi bildirmişdir.
İngiltərənin "Surrey" Universitetinin alimləri, yaşıl çayda olan təbii antioksidantın antibiotiklərə qarşı davamlı olan, təhlükəli infeksiyalara qarşı mübarizədə faydalı ola biləcəyini müəyyən edib. Bu barədə "MedicalXpress" agentliyi bildirmişdir.
Tədqiqatçılar, epiqallokatexinin, infeksiyaların müalicəsində istifadə edilən, antibakterial aztreonama preparatının təsirini aktivləşdirməsini müəyyən etmişdir.
Antioksidant və antibiotikin birləşməsi bu maddələrin hər birindən ayrı olaraq, daha təsirli olduğunu sübut edir. Bu vitro təcrübələri zamanı müəyyən edilmişdir.
Epiqallokatexinin, "P.aeruginosa " antibiotikin həzm edilməsinə kömək edir. Pseudomonas aeruginosa, insanlar üçün şərti olan mənfi bakteriyadır. O, əsasən immuniteti zəifləmiş insanları yoluxdurur. Ona, çox vaxt iltihablı yaralarda və sistitdə rast gəlmək olar.
Ümumdünya Səhiyyə Təşkilatı, mikroorqanizmin dərmanlara qarşı dayanıqlı olduğuna görə, insan sağlamlığı üçün təhlükəli hesab edilən, mikroorqanizmlər siyahısına daxil etmişdir. Bu, superinfeksiyaya - bütün əsas dərmanlara davamlı olan ikinci dərəcəli infeksiyalara səbəb olur.
Milli.Az /news.milli.az










 Hakışta
Hakışta Mükəmməl seks üçün yataqdakı QAYDALAR
Mükəmməl seks üçün yataqdakı QAYDALAR İdeal Dieta: 1 həftəyə 5 kq arıqla!
İdeal Dieta: 1 həftəyə 5 kq arıqla! Cəfərinin insan orqanizminə inanılmaz faydaları
Cəfərinin insan orqanizminə inanılmaz faydaları Qara zirə (Çörək otunun) faydaları
Qara zirə (Çörək otunun) faydaları Qarazirə hər dərdin çarəsi olan bitki
Qarazirə hər dərdin çarəsi olan bitki Ən güclü təbii antibiotik: Udi hindi bitkisinin faydaları
Ən güclü təbii antibiotik: Udi hindi bitkisinin faydaları Fatih Terim azərbaycanlı müğənni ilə bir arada — FOTOLAR
Fatih Terim azərbaycanlı müğənni ilə bir arada — FOTOLAR Hər gün etdiyiniz bir vərdiş həyatınızı xilas edə bilər
Hər gün etdiyiniz bir vərdiş həyatınızı xilas edə bilər Gözümüzü məhv edə biləcək eynəklər var
Gözümüzü məhv edə biləcək eynəklər var Arıqlamağa mane olan 3 böyük səhv
Arıqlamağa mane olan 3 böyük səhv Şaftalının faydaları nələrdir, neçə kaloridir?
Şaftalının faydaları nələrdir, neçə kaloridir? "Yağlı dəriyə yağ çəkilməz" mifinin sonu: Sebumu jojoba ilə ram edin
"Yağlı dəriyə yağ çəkilməz" mifinin sonu: Sebumu jojoba ilə ram edin